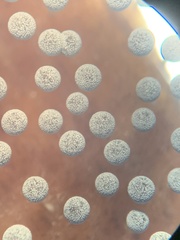
Physarum globuliferum
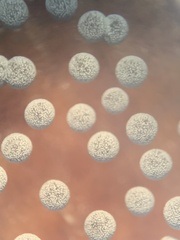
Physarum globuliferum

Physarum globuliferum: taxon details and analytics
- Domain
- Kingdom
- Protozoa
- Phylum
- Mycetozoa
- Class
- Myxomycetes
- Order
- Physarales
- Family
- Physaraceae
- Genus
- Physarum
- Species
- Physarum globuliferum
- Scientific Name
- Physarum globuliferum
Summary description from Wikipedia:
Bol kalkkopje
Het bol kalkkopje (Physarum globuliferum) is een slijmzwam behorend tot de familie Physaraceae. Het komt voor in naaldbos of gemengd bos. Het leeft saprotroof op dood naaldhout.
...Physarum globuliferum in languages:
- Czech
- vápenatka kulonosná
- Dutch
- Bol kalkkopje
- Finnish
- pallosolmunen
Images from inaturalist.org observations:
We recommend you sign up for this excellent, free service.
Parent Taxon
Sibling Taxa
- Physarum aeneum
- Physarum albescens
- Physarum album
- Physarum alexandrowiczii
- Physarum alpestre
- Physarum alpinum
- Physarum apiculosporum
- Physarum auripigmentum
- Physarum auriscalpium
- Physarum bethelii
- Physarum bitectum
- Physarum bivalve
- Physarum bogoriense
- Physarum brunneolum
- Physarum caesiellum
- Physarum carneum
- Physarum cinereum
- Physarum citrinum
- Physarum compressum
- Physarum confertum
- Physarum contextum
- Physarum corticola
- Physarum crateriforme
- Physarum cremiluteum
- Physarum daamsii
- Physarum decipiens
- Physarum dictyospermum
- Physarum diderma
- Physarum didermoides
- Physarum digitatum
- Physarum echinosporum
- Physarum flavicomum
- Physarum flavidum
- Physarum galbeum
- Physarum globuliferum
- Physarum gravidum
- Physarum gyrosum
- Physarum hongkongense
- Physarum javanicum
- Physarum lateritium
- Physarum leucophaeum
- Physarum leucopus
- Physarum licheniforme
- Physarum loratum
- Physarum luteolum
- Physarum megalosporum
- Physarum melleum
- Physarum murinum
- Physarum mutabile
- Physarum nicaraguense
- Physarum nigripodium
- Physarum nitens
- Physarum nivale
- Physarum notabile
- Physarum nucleatum
- Physarum nudum
- Physarum oblatum
- Physarum obscurum
- Physarum ovisporum
- Physarum penetrale
- Physarum pezizoideum
- Physarum plicatum
- Physarum polycephalum
- Physarum psittacinum
- Physarum pulcherrimum
- Physarum pulcherripes
- Physarum pusillum
- Physarum retisporum
- Physarum rigidum
- Physarum roseum
- Physarum rubiginosum
- Physarum schroeteri
- Physarum scoticum
- Physarum serpula
- Physarum spectabile
- Physarum stellatum
- Physarum straminipes
- Physarum sulphureum
- Physarum superbum
- Physarum tenerum
- Physarum vernum
- Physarum virescens
- Physarum viride